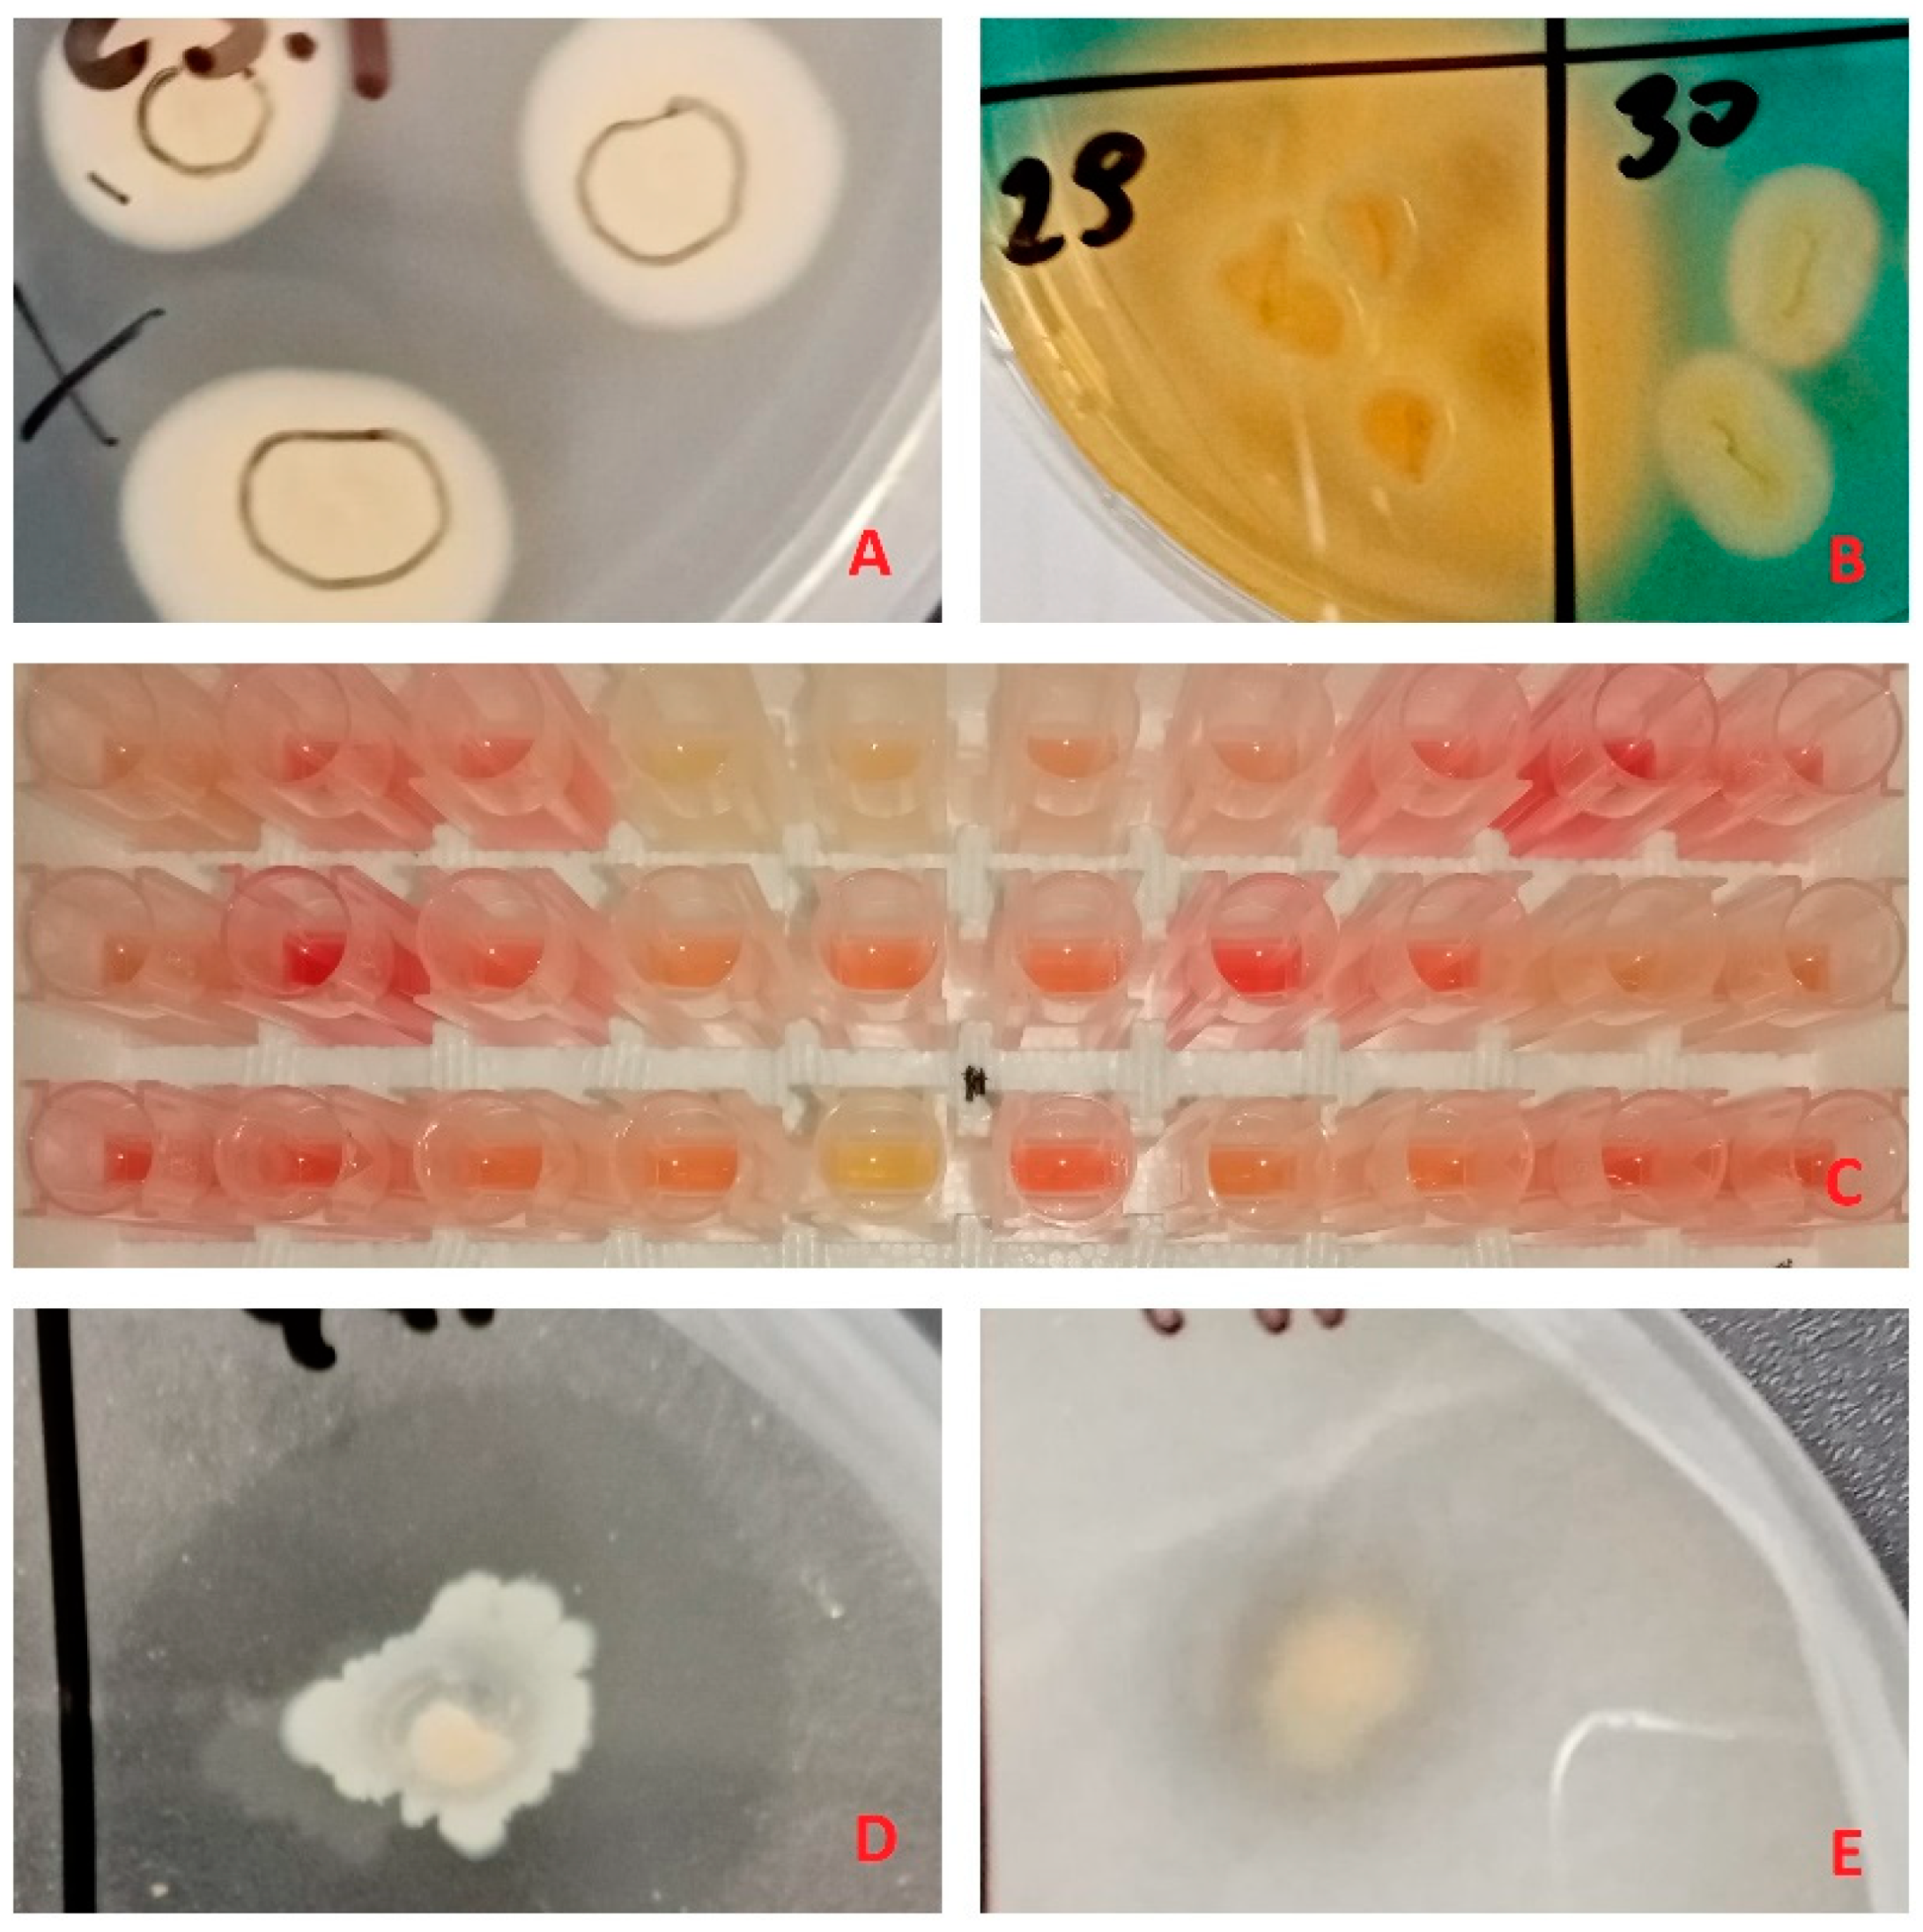
Microorganisms 09 01151 g001 Microorganisms 09 01151 g001

Oak (Quercus robur) Associated Endophytic Paenibacillus sp. Promotes Poplar (Populus spp.) Root Growth In Vitro
Abstract
1. Introduction
2. Materials and Methods
2.1. Isolation and Identification
2.2. Plant Growth Promoting Traits
2.3. Poplar Microshoot Inoculation
3. Results
3.1. Isolation and Identification
3.2. Plant Growth Promoting Traits
3.3. Poplar microshoot inoculation
4. Discussion
5. Conclusions
Author Contributions
Funding
Institutional Review Board Statement
Informed Consent Statement
Data Availability Statement
Conflicts of Interest
References
- Kour, D.; Rana, K.L.; Yadav, A.N.; Yadav, N.; Kumar, M.; Kumar, V.; Vyas, P.; Dhaliwal, H.S.; Saxena, A.K. Microbial biofertilizers: Bioresources and eco-friendly technologies for agricultural and environmental sustainability. Biocatal. Agric. Biotechnol. 2020, 23, 101487. [Google Scholar] [CrossRef]
- García-Fraile, P.; Menendez, E.; Rivas, R. Role of bacterial biofertilizers in agriculture and forestry. AIMS Environ. Sci. 2015, 2, 183–205. [Google Scholar] [CrossRef]
- Suhag, M. Potential of Biofertilizers to Replace Chemical Fertilizers. Int. Adv. Res. J. Sci. Eng. Technol. 2016, 3, 163–167. [Google Scholar]
- Pirttilä, A.M.; Mohammad Parast Tabas, H.; Baruah, N.; Koskimäki, J.J. Biofertilizers and Biocontrol Agents for Agriculture: How to Identify and Develop New Potent Microbial Strains and Traits. Microorganisms 2021, 9, 817. [Google Scholar] [CrossRef] [PubMed]
- Suman, A.; Yadav, A.N.; Verma, P. Endophytic microbes in crops: Diversity and beneficial impact for sustainable agriculture. In Microbial Inoculants in Sustainable Agricultural Productivity: Vol. 1: Research Perspectives; Springer: New Delhi, India, 2016; pp. 117–143. [Google Scholar] [CrossRef]
- Grady, E.N.; MacDonald, J.; Liu, L.; Richman, A.; Yuan, Z.C. Current knowledge and perspectives of Paenibacillus: A review. Microb. Cell Fact. 2016, 15, 203. [Google Scholar] [CrossRef] [PubMed]
- Ren, H.; Qin, X.; Huang, B.; Fernández-García, V.; Lv, C. Responses of soil enzyme activities and plant growth in a eucalyptus seedling plantation amended with bacterial fertilizers. Arch. Microbiol. 2020, 202, 1381–1396. [Google Scholar] [CrossRef] [PubMed]
- Khosro, M.; Yousef, S. Bacterial Biofertilizers for Sustainable Crop Production: A Review. ARPN J. Agric. Bol. Sci. 2012, 7, 307–316. [Google Scholar]
- Prasad, H.; Sajwan, P.; Kumari, M.; Solanki, S. Effect of organic manures and biofertilizer on plant growth, yield and quality of horticultural crop: A review. Int. J. Chem. Stud. 2017, 5, 217–221. [Google Scholar]
- Fan, D.; Subramanian, S.; Smith, D.L. Plant endophytes promote growth and alleviate salt stress in Arabidopsis thaliana. Sci. Rep. 2020, 10, 12740. [Google Scholar] [CrossRef]
- Kalayu, G. Phosphate Solubilizing Microorganisms: Promising Approach as Biofertilizers. Int. J. Agron. 2019, 2019, 1–7. [Google Scholar] [CrossRef]
- Gothwal, R.K.; Nigam, V.K.; Mohan, M.K.; Sasmal, D.; Ghosh, P. Screening of nitrogen fixers from rhizospheric bacterial isolates associated with important desert plants. Appl. Ecol. Environ. Res. 2008, 6, 101–109. [Google Scholar] [CrossRef]
- Ferreira, C.M.H.; Vilas-Boas, Â.; Sousa, C.A.; Soares, H.M.V.M.; Soares, E.V. Comparison of five bacterial strains producing siderophores with ability to chelate iron under alkaline conditions. AMB Express 2019, 9, 78. [Google Scholar] [CrossRef] [PubMed]
- Mani, R.; Rajkumar, M.; Moreno, A.; Zhang, C.; Freitas, H. Serpentine endophytic bacterium Pseudomonas azotoformans ASS1 accelerates phytoremediation of soil metals under drought stress. Chemosphere 2017, 185, 75–85. [Google Scholar]
- Vessey, J.K. Plant growth promoting rhizobacteria as biofertilizers. Plant Soil 2003, 255, 571–586. [Google Scholar] [CrossRef]
- Chakraborty, U.; Chakraborty, B.; Basnet, M. Plant growth promotion and induction of resistance in Camellia sinensis by Bacillus megaterium. J. Basic Microbiol. 2006, 46, 186–195. [Google Scholar] [CrossRef]
- Govindasamy, V.; Senthilkumar, M.; Magheshwaran, V.; Kumar, U.; Bose, P.; Sharma, V.; Annapurna, K. Bacillus and Paenibacillus spp.: Potential PGPR for Sustainable Agriculture. Plant Growth Health Promot. Bact. 2010, 18, 333–356. [Google Scholar]
- Puri, A.; Padda, K.P.; Chanway, C.P. Can naturally-occurring endophytic nitrogen-fixing bacteria of hybrid white spruce sustain boreal forest tree growth on extremely nutrient-poor soils? Soil Biol. Biochem. 2020, 140, 107642. [Google Scholar] [CrossRef]
- Barra, P.J.; Inostroza, N.G.; Mora, M.L.; Crowley, D.E.; Jorquera, M.A. Bacterial consortia inoculation mitigates the water shortage and salt stress in an avocado (Persea americana Mill.) nursery. Appl. Soil Ecol. 2017, 111, 39–47. [Google Scholar] [CrossRef]
- Anand, R.; Chanway, C. N2-fixation and growth promotion in cedar colonized by an endophytic strain of Paenibacillus polymyxa. Biol. Fertil. Soils 2012, 49, 235–239. [Google Scholar] [CrossRef]
- Oliveira, A.L.M.; Urquiaga, S.; Döbereiner, J.; Baldani, J.I. The effect of inoculating endophytic N2-fixing bacteria on micropropagated sugarcane plants. Plant Soil 2002, 242, 205–215. [Google Scholar] [CrossRef]
- Iniguez, A.L.; Dong, Y.; Triplett, E.W. Nitrogen Fixation in Wheat Provided by Klebsiella pneumoniae 342. Mol. Plant-Microbe Interactions 2004, 17, 1078–1085. [Google Scholar] [CrossRef]
- Tamošiūnė, I.; Stanienė, G.; Haimi, P.; Stanys, V.; Rugienius, R.; Baniulis, D. Endophytic Bacillus and Pseudomonas spp. Modulate Apple Shoot Growth, Cellular Redox Balance, and Protein Expression Under In vitro Conditions. Front. Plant Sci. 2018, 9, 889. [Google Scholar] [CrossRef]
- Liu, D.; Yang, Q.; Ge, K.; Hu, X.; Qi, G.; Du, B.; Liu, K.; Ding, Y. Promotion of iron nutrition and growth on peanut by Paenibacillus illinoisensis and Bacillus sp. strains in calcareous soil. Braz. J. Microbiol. 2017, 48, 656–670. [Google Scholar] [CrossRef] [PubMed]
- Adesemoye, A.O.; Torbert, H.A.; Kloepper, J.W. Plant Growth-Promoting Rhizobacteria Allow Reduced Application Rates of Chemical Fertilizers. Microb. Ecol. 2009, 58, 921–929. [Google Scholar] [CrossRef] [PubMed]
- Song, Z.; Lu, Y.; Liu, X.; Wei, C.; Oladipo, A.; Fan, B. Evaluation ofPantoea eucalyptiFBS135 for pine (Pinus massoniana) growth promotion and its genome analysis. J. Appl. Microbiol. 2020, 129, 958–970. [Google Scholar] [CrossRef] [PubMed]
- Abd El-Migeed, M.M.M.; Saleh, M.M.S.; Mostafa, E.A.M. The Beneficial Effect of Minimizing Mineral Nitrogen Fertilization on Washington Navel Orange Trees by Using Organic and Biofertilizers. World J. Agric. Sci. 2007, 3, 80–85. [Google Scholar]
- Dobo, B.; Asefa, F.; Asfaw, Z. Phosphorus Requirement for Colonization by Arbuscular Mycorrhizal Fungi (AMF) and Effect of AMF Inoculants on Growth of Perennial Crops and Agroforestry Trees. East Afr. J. Sci. 2016, 10, 77–86. [Google Scholar]
- Abd-Alhamid, N.; Hassan, H.S.A.; Haggag, L.F.; Hassan, A.M. Effect of mineral and bio-fertilization on vegetative growth, leaf mineral contents and flowering of manzanillo olive trees. Int. J. ChemTech Res. 2015, 8, 51–61. [Google Scholar]
- Abdou, M.A.H.; Ahmed, E.E.T.; Ahmed, A.A.; Abdel-Mola, M.A.M. Response of Populus nigra, L. seedlings to compost, biofertilizers and mineral npk fertilization. Minia J. Agric. Res. Dev. 2014, 34, 31–47. [Google Scholar]
- Gouda, S.; Das, G.; Sen, S.K.; Shin, H.-S.; Patra, J.K. Endophytes: A Treasure House of Bioactive Compounds of Medicinal Importance. Front. Microbiol. 2016, 7, 1538. [Google Scholar] [CrossRef]
- Strobel, G. The Emergence of Endophytic Microbes and Their Biological Promise. J. Fungi 2018, 4, 57. [Google Scholar] [CrossRef] [PubMed]
- Campanile, G.; Ruscelli, A.; Luisi, N. Antagonistic activity of endophytic fungi towards Diplodia corticola assessed by in vitro and in planta tests. Eur. J. Plant Pathol. 2007, 117, 237–246. [Google Scholar] [CrossRef]
- Shiono, Y.; Koyama, H.; Murayama, T.; Koseki, T. New sesquiterpenes from the endophyte Microdiplodia sp. TT-12 and their antimicrobial activity. Phytochem. Lett. 2015, 14, 143–147. [Google Scholar] [CrossRef]
- Ulrich, K.; Ulrich, A.; Ewald, D. Diversity of endophytic bacterial communities in poplar grown under field conditions. FEMS Microbiol. Ecol. 2008, 63, 169–180. [Google Scholar] [CrossRef]
- Scherling, C.; Ulrich, K.; Ewald, D.; Weckwerth, W. A Metabolic Signature of the Beneficial Interaction of the Endophyte Paenibacillus sp. Isolate and In Vitro–Grown Poplar Plants Revealed by Metabolomics. Mol. Plant-Microbe Interact. 2009, 22, 1032–1037. [Google Scholar] [CrossRef]
- Lloyd, G.; McCown, B.H. Commercially feasible micropropagation of mountain laurel, (Kalmia latifolia) by use of shoot tip culture. Comb. Proc. Int. Plant Propagators’ Soc. 1980, 30, 421–427. [Google Scholar]
- Bertani, G. Studies on lysogenesis. I. The mode of phage liberation by lysogenic Escherichia coli. J. Bacteriol. 1951, 62, 293–300. [Google Scholar] [CrossRef]
- Jasim, B.; Anish, M.C.; Shimil, V.; Jyothis, M.; Radhakrishnan, E.K. Studies on Plant Growth Promoting Properties of Fruit-Associated Bacteria from Elettaria cardamomum and Molecular Analysis of ACC Deaminase Gene. Appl. Biochem. Biotechnol. 2015, 177, 175–189. [Google Scholar] [CrossRef]
- Chen, Q.; Liu, S. Identification and Characterization of the Phosphate-Solubilizing Bacterium Pantoea sp. S32 in Reclamation Soil in Shanxi, China. Front. Microbiol. 2019, 10, 2171. [Google Scholar] [CrossRef]
- Arora, N.K.; Verma, M. Modified microplate method for rapid and efficient estimation of siderophore produced by bacteria. 3 Biotech 2017, 7, 381. [Google Scholar] [CrossRef]
- Schwyn, B.; Neilands, J. Universal chemical assay for the detection and determination of siderophores. Anal. Biochem. 1987, 160, 47–56. [Google Scholar] [CrossRef]
- Gordon, S.A.; Weber, R.P. Colorimetric estimation of indole-3-acetic acid. Plant Pysiol. 1950, 72, 192–195. [Google Scholar]
- Gottel, N.R.; Castro, H.; Kerley, M.; Yang, Z.; Pelletier, D.A.; Podar, M.; Karpinets, T.; Uberbacher, E.; Tuskan, G.A.; Vilgalys, R.; et al. Distinct Microbial Communities within the Endosphere and Rhizosphere of Populus deltoides Roots across Contrasting Soil Types. Appl. Environ. Microbiol. 2011, 77, 5934–5944. [Google Scholar] [CrossRef]
- Cregger, M.A.; Carper, D.L.; Christel, S.; Doktycz, M.J.; Labbé, J.; Michener, J.K.; Dove, N.C.; Johnston, E.R.; Moore, J.A.M.; Vélez, J.M.; et al. Plant–Microbe Interactions: From Genes to Ecosystems Using Populus as a Model System. Phytobiomes J. 2021, 5, 29–38. [Google Scholar] [CrossRef]
- Beckers, B.; De Beeck, M.O.; Thijs, S.; Truyens, S.; Weyens, N.; Boerjan, W.; Vangronsveld, J. Performance of 16s rDNA Primer Pairs in the Study of Rhizosphere and Endosphere Bacterial Microbiomes in Metabarcoding Studies. Front. Microbiol. 2016, 7, 650. [Google Scholar] [CrossRef] [PubMed]
- Carrell, A.A.; Frank, A.C. Pinus flexilis and Piceae engelmannii share a simple and consistent needle endophyte microbiota with a potential role in nitrogen fixation. Front. Microbiol. 2014, 5, 333. [Google Scholar] [CrossRef]
- Gulati, A.; Sood, S.; Rahi, P.; Thakur, R.; Chauhan, S.; Chawla, I. Diversity analysis of diazotrophic bacteria associated with the roots of tea (Camellia sinensis (L.) O. Kuntze). J. Microbiol. Biotechnol. 2011, 21, 545–555. [Google Scholar] [CrossRef] [PubMed]
- Sapp, M.; Lewis, E.; Moss, S.; Barrett, B.; Kirk, S.; Elphinstone, J.G.; Denman, S. Metabarcoding of Bacteria Associated with the Acute Oak Decline Syndrome in England. Forests 2016, 7, 95. [Google Scholar] [CrossRef]
- Meaden, S.; Metcalf, C.J.E.; Koskella, B. The effects of host age and spatial location on bacterial community composition in the English oak tree (Quercus robur). Environ. Microbiol. Rep. 2016, 8, 649–658. [Google Scholar] [CrossRef] [PubMed]
- Weyens, N.; Taghavi, S.; Barac, T.; van der Lelie, D.; Boulet, J.; Artois, T.; Carleer, R.; Vangronsveld, J. Bacteria associated with oak and ash on a TCE-contaminated site: Characterization of isolates with potential to avoid evapotranspiration of TCE. Environ. Sci. Pollut. Res. 2009, 16, 830–843. [Google Scholar] [CrossRef]
- Bueno-Gonzalez, V.; Brady, C.; Denman, S.; Allainguillaume, J.; Arnold, D. Pseudomonas kirkiae sp. nov., a novel species isolated from oak in the United Kingdom, and phylogenetic considerations of the genera Pseudomonas, Azotobacter and Azomonas. Int. J. Syst. Evol. Microbiol. 2020, 70, 2426–2434. [Google Scholar] [CrossRef]
- Akbari Kiarood, S.L.; Rahnama, K.; Golmohammadi, M.; Nasrollanejad, S. Quorum-quenching endophytic bacteria inhibit disease caused by Pseudomonas syringae pv. syringae in Citrus cultivars. J. Basic Microbiol. 2020. [Google Scholar] [CrossRef] [PubMed]
- Ulrich, K.; Becker, R.; Behrendt, U.; Kube, M.; Ulrich, A. A Comparative Analysis of Ash Leaf-Colonizing Bacterial Communities Identifies Putative Antagonists of Hymenoscyphus fraxineus. Front. Microbiol. 2020, 11, 966. [Google Scholar] [CrossRef]
- Izumi, H.; Anderson, I.C.; Killham, K.; Moore, E.R.B. Diversity of predominant endophytic bacteria in European deciduous and coniferous trees. Can. J. Microbiol. 2008, 54, 173–179. [Google Scholar] [CrossRef] [PubMed]
- Bal, A.; Anand, R.; Berge, O.; Chanway, C.P. Isolation and identification of diazotrophic bacteria from internal tissues of pinus contorta and thuja plicata. Botany 2012, 90, 891–896. [Google Scholar] [CrossRef]
- Brooks, D.; Gonzalez, C.; Appel, D.; Filer, T. Evaluation of Endophytic Bacteria as Potential Biological-Control Agents for Oak Wilt. Biol. Control. 1994, 4, 373–381. [Google Scholar] [CrossRef]
- Ulrich, K.; Stauber, T.; Ewald, D. Paenibacillus—A predominant endophytic bacterium colonising tissue cultures of woody plants. Plant Cell Tissue Organ Cult. (PCTOC) 2008, 93, 347–351. [Google Scholar] [CrossRef]
- Hoang, H.; Tran, L.H.; Nguyen, T.H.; Nguyen, D.A.T.; Nguyen, H.H.T.; Pham, N.B.; Trinh, P.Q.; De Boer, T.; Brouwer, A.; Chu, H.H. Occurrence of endophytic bacteria in Vietnamese Robusta coffee roots and their effects on plant parasitic nematodes. Symbiosis 2019, 80, 75–84. [Google Scholar] [CrossRef]
- Kong, P. Evaluation of a novel endophytic Pseudomonas lactis strain for control of boxwood blight1. J. Environ. Hortic. 2019, 37, 39–43. [Google Scholar] [CrossRef]
- Ferreira, A.; Quecine, M.C.; Lacava, P.T.; Oda, S.; Azevedo, J.L.; Araújo, W.L. Diversity of endophytic bacteria from Eucalyptus species seeds and colonization of seedlings by Pantoea agglomerans. FEMS Microbiol. Lett. 2008, 287, 8–14. [Google Scholar] [CrossRef]
- Radhakrishnan, R.; Hashem, A.; Allah, E.F.A. Bacillus: A Biological Tool for Crop Improvement through Bio-Molecular Changes in Adverse Environments. Front. Physiol. 2017, 8, 667. [Google Scholar] [CrossRef]
- Ubalde, M.C.; Braña, V.; Sueiro, F.; Morel, M.A.; Martínez-Rosales, C.; Marquez, C.; Castro-Sowinski, S. The Versatility of Delftia sp. Isolates as Tools for Bioremediation and Biofertilization Technologies. Curr. Microbiol. 2012, 64, 597–603. [Google Scholar] [CrossRef] [PubMed]
- Feng, Y.; Shen, D.; Song, W. Rice endophyte Pantoea agglomerans YS19 promotes host plant growth and affects allocations of host photosynthates. J. Appl. Microbiol. 2006, 100, 938–945. [Google Scholar] [CrossRef] [PubMed]
- da Silveira, A.P.D.; Iório, R.d.F.; Marcos, F.C.C.; Fernandes, A.O.; de Souza, S.A.C.D.; Kuramae, E.E.; Cipriano, M.A.P. Exploitation of new endophytic bacteria and their ability to promote sugarcane growth and nitrogen nutrition. Antonie van Leeuwenhoek Int. J. Gen. Mol. Microbiol. 2019, 112, 283–295. [Google Scholar] [CrossRef] [PubMed]
- Nelson, D.M.; Glawe, A.J.; Labeda, D.P.; Cann, I.K.O.; Mackie, R.I. Paenibacillus tundrae sp. nov. and Paenibacillus xylanexedens sp. nov., psychrotolerant, xylan-degrading bacteria from Alaskan tundra. Int. J. Syst. Evol. Microbiol. 2009, 59, 1708–1714. [Google Scholar]
- Rasimus, S.; Mikkola, R.; Andersson, M.A.; Teplova, V.V.; Venediktova, N.; Ek-Kommonen, C.; Salkinoja-Salonen, M. Psychrotolerant Paenibacillus tundrae Isolates from Barley Grains Produce New Cereulide-Like Depsipeptides (Paenilide and Homopaenilide) That Are Highly Toxic to Mammalian Cells. Appl. Environ. Microbiol. 2012, 78, 3732–3743. [Google Scholar] [CrossRef]
- Goswami, D.; Parmar, S.; Vaghela, H.; Dhandhukia, P.; Thakker, J. Describing Paenibacillus mucilaginosus strain N3 as an efficient plant growth promoting rhizobacteria (PGPR). Cogent Food Agric. 2015, 1, 1000714. [Google Scholar] [CrossRef]
- Yu, Q.; Tigerstedt, P.M.A.; Haapanen, M. Growth and phenology hybrid aspen clones (Populus tremula L. x Populus tremuloides Michx.). Silva Fenn. 2001, 35, 15–25. [Google Scholar] [CrossRef]
- Tullus, A.; Tullus, H.; Vares, A.; Kanal, A. Early growth of hybrid aspen (Populus×wettsteinii Hämet-Ahti) plantations on former agricultural lands in Estonia. For. Ecol. Manag. 2007, 245, 118–129. [Google Scholar]
- Khasa, D.; Fung, M.; Logan, B. Early growth response of container-grown selected woody boreal seedlings in amended composite tailings and tailings sand. Bioresour. Technol. 2005, 96, 857–864. [Google Scholar] [CrossRef]
- Fu, J.; Sampalo, R.; Gallardo, F.; Cánovas, F.M.; Kirby, E.G. Assembly of a cytosolic pine glutamine synthetase holoenzyme in leaves of transgenic poplar leads to enhanced vegetative growth in young plants. Plant, Cell Environ. 2003, 26, 411–418. [Google Scholar] [CrossRef]
- Idris, E.E.; Iglesias, D.J.; Talon, M.; Borriss, R. Tryptophan-Dependent Production of Indole-3-Acetic Acid (IAA) Affects Level of Plant Growth Promotion by Bacillus amyloliquefaciens FZB42. Mol. Plant-Microbe Interactions 2007, 20, 619–626. [Google Scholar] [CrossRef]
- Wang, S.; Ouyang, L.; Ju, X.; Zhang, L.; Zhang, Q.; Li, Y. Survey of Plant Drought-Resistance Promoting Bacteria from Populus euphratica Tree Living in Arid Area. Indian J. Microbiol. 2014, 54, 419–426. [Google Scholar] [CrossRef] [PubMed]
- Tiwari, S.; Lata, C.; Chauhan, P.S.; Nautiyal, C.S. Pseudomonas putida attunes morphophysiological, biochemical and molecular responses in Cicer arietinum L. during drought stress and recovery. Plant Physiol. Biochem. 2016, 99, 108–117. [Google Scholar] [CrossRef] [PubMed]
- Bal, H.B.; Das, S.; Dangar, T.K.; Adhya, T.K. ACC deaminase and IAA producing growth promoting bacteria from the rhizosphere soil of tropical rice plants. J. Basic Microbiol. 2013, 53, 972–984. [Google Scholar] [CrossRef] [PubMed]
- Qin, S.; Miao, Q.; Feng, W.-W.; Wang, Y.; Zhu, X.; Xing, K.; Jiang, J.-H. Biodiversity and plant growth promoting traits of culturable endophytic actinobacteria associated with Jatropha curcas L. growing in Panxi dry-hot valley soil. Appl. Soil Ecol. 2015, 93, 47–55. [Google Scholar] [CrossRef]
- Goryluk-Salmonowicz, A.; Orzeszko-Rywka, A.; Piórek, M.; Rekosz-Burlaga, H.; Otłowska, A.; Gozdowski, D.; Błaszczyk, M. Plant Growth Promoting Bacterial Endophytes Isolated from Polish Herbal Plants. Acta Sci. Pol. Hortorum Cultus 2018, 17, 101–110. [Google Scholar] [CrossRef]
- Devi, K.A.; Pandey, G.; Rawat, A.K.S.; Sharma, G.D.; Pandey, P. The Endophytic Symbiont—Pseudomonas aeruginosa Stimulates the Antioxidant Activity and Growth of Achyranthes aspera L. Front. Microbiol. 2017, 8, 1897. [Google Scholar] [CrossRef]

| Sequencing Analysis | Plant Growth Promoting Traits | ||||||||
|---|---|---|---|---|---|---|---|---|---|
| Source Tree Designation | Fragment Length, bp | Closest NCBI Match, Accession no. | % Identity | Query Coverage, % | Siderophore Production | Phosphate Solubilization/Mineralization | Nitrogen Fixation | IAA Production, µg/mL | |
| Pi | Po | ||||||||
| 4 | 1464 | Delftia lacustris 332, NR_116495.1 | 99.86 | 100 | - | + | + | + | 16.36 |
| 1 | 1477 | Paenibacillus tundrae A10b, NR_044525.1 | 99.32 | 99 | - | + | + | - | 25 |
| 3 | 1486 | Paenibacillus tundrae A10b, NR_044525.1 | 99.53 | 99 | - | + | + | - | 29.2 |
| I1 | 1483 | Bacillus aryabhattai B8W22, NR_115953.1 | 99.93 | 99 | - | + | + | + | 7.4 |
| I1 | 1483 | Bacillus aryabhattai B8W22, NR_115953.1 | 99.80 | 99 | - | + | + | + | 13.6 |
| 2 | 1469 | Pseudomonas brenneri CFML 97-391, NR_025103.1 | 99.86 | 99 | + | + | + | + | 17.5 |
| I2 | 1462 | Pseudomonas azotoformans NBRC 12693, NR_113600.1 | 99.73 | 99 | + | + | + | + | 17.5 |
| 3 | 1483 | Paenibacillus tundrae A10b, NR_044525.1 | 99.46 | 100 | - | + | + | - | 27.2 |
| 1 | 1395 | Pantoea agglomerans DSM 3493, NR_041978.1 | 99.64 | 100 | - | + | + | + | 50 |
| I2 | 1486 | Paenibacillus tundrae A10b, NR_044525.1 | 99.39 | 99 | - | + | + | - | 27.22 |
| 2 | 1473 | Pseudomonas proteolytica CMS 64, NR_025588.1 | 99.59 | 99 | + | + | + | + | 13.2 |
| 1 | 1411 | Pantoea agglomerans DSM 3493, NR_041978.1 | 99.65 | 100 | - | + | + | + | 67.6 |
| I2 | 1485 | Paenibacillus tundrae A10b, NR_044525.1 | 99.53 | 99 | - | + | + | - | 28.4 |
| 1 | 1461 | Pseudomonas azotoformans NBRC 12693, NR_113600.1 | 99.66 | 99 | + | + | + | + | 18.2 |
| 1 | 1470 | Pseudomonas azotoformans NBRC 12693, NR_113600.1 | 99.66 | 99 | + | + | + | + | 19.2 |
| 1 | 1488 | Paenibacillus tundrae A10b, NR_044525.1 | 99.46 | 99 | - | + | + | - | 25.6 |
| 1 | 1459 | Pantoea agglomerans DSM 3493, NR_041978.1 | 99.97 | 99 | - | + | + | + | 41.7 |
| 2 | 1484 | Paenibacillus tundrae A10b, NR_044525.1 | 99.39 | 99 | - | + | + | - | 27 |
| 1 | 1469 | Pseudomonas azotoformans NBRC 12693, NR_113600.1 | 99.66 | 99 | + | + | + | + | 16.4 |
| 2 | 1472 | Pseudomonas azotoformans NBRC 12693, NR_113600.1 | 99.73 | 99 | + | + | + | + | 18.3 |
| I1 | 1486 | Paenibacillus tundrae A10b, NR_044525.1 | 99.33 | 99 | - | + | + | - | 31.6 |
| 3 | 1490 | Paenibacillus tundrae A10b, NR_044525.1 | 99.39 | 99 | - | + | + | - | 26.9 |
| 3 | 1467 | Pseudomonas azotoformans NBRC 12693, NR_113600.1 | 99.73 | 99 | + | + | + | + | 19.2 |
| 1 | 1469 | Pseudomonas azotoformans NBRC 12693, NR_113600.1 | 99.66 | 99 | + | + | + | + | 17 |
| S2 | 1492 | Bacillus aryabhattai B8W22, NR_115953.1 | 99.80 | 99 | - | + | + | + | 8.8 |
| S2 | 1481 | Paenibacillus tundrae A10b, NR_044525.1 | 99.53 | 99 | - | + | + | - | 25.2 |
| 3 | 1474 | Pseudomonas proteolytica CMS 64, NR_025588.1 | 99.66 | 99 | + | + | + | + | 17 |
| 3 | 1472 | Pseudomonas azotoformans NBRC 12693, NR_113600.1 | 99.73 | 99 | + | + | + | + | 17.5 |
| 3 | 1494 | Paenibacillus tundrae A10b, NR_044525.1 | 99.53 | 99 | - | + | + | - | 22.4 |
| 3 | 1487 | Paenibacillus tundrae A10b, NR_044525.1 | 99.53 | 99 | - | + | + | - | 26.4 |
| 3 | 1324 | Pseudomonas paralactis DSM 29164, NR_156987.1 | 99.85 | 100 | + | + | + | + | 17.6 |
| 3 | 1354 | Paenibacillus tundrae A10b, NR_044525.1 | 99.34 | 99 | - | + | + | - | 25.02 |
| 1 | 1466 | Pseudomonas azotoformans NBRC 12693, NR_113600.1 | 99.73 | 99 | + | + | + | + | 16.4 |
| 1 | 1454 | Pseudomonas azotoformans NBRC 12693, NR_113600.1 | 99.72 | 99 | + | + | + | + | 11.6 |
| 2 | 1467 | Pseudomonas azotoformans NBRC 12693, NR_113600.1 | 99.73 | 99 | + | + | + | + | 17.5 |
| 2 | 1460 | Pseudomonas azotoformans NBRC 12693, NR_113600.1 | 99.79 | 99 | + | + | + | + | 15 |
| 3 | 1487 | Paenibacillus tundrae A10b, NR_044525.1 | 99.53 | 100 | - | + | + | - | 25 |
| 3 | 1475 | Bacillus firmus NBRC 15306, NR_112635.1 | 98.17 | 100 | - | + | - | + | 13.2 |
| 1 | 1465 | Pseudomonas azotoformans NBRC 12693, NR_113600.1 | 99.66 | 99 | + | + | + | + | 24.4 |
| I2 | 1326 | Paenibacillus oceanisediminis L10, NR_118217.1 | 98.93 | 99 | - | + | + | - | 25.04 |
| I2 | 1484 | Paenibacillus tundrae A10b, NR_044525.1 | 99.46 | 99 | - | + | + | - | 21.08 |
| 4 | 1339 | Delftia lacustris 332, NR_116495.1 | 99.85 | 99 | - | + | + | + | 15.2 |
| 3 | 1493 | Pseudomonas azotoformans NBRC 12693, NR_113600.1 | 98.18 | 99 | + | + | + | + | 18.16 |
| 3 | 1483 | Paenibacillus tundrae A10b, NR_044525.1 | 99.46 | 100 | - | + | + | - | 30 |
| 3 | 1483 | Bacillus firmus NBRC 15306, NR_112635.1 | 98.92 | 99 | - | + | - | + | 11.2 |
| 4 | 1468 | Pseudomonas azotoformans NBRC 12693, NR_113600.1 | 99.79 | 99 | + | + | + | + | 27 |
| 4 | 1489 | Delftia lacustris 332, NR_116495.1 | 98.39 | 100 | - | + | + | + | 17 |
| I2 | 1490 | Paenibacillus tundrae A10b, NR_044525.1 | 99.60 | 99 | - | + | + | - | 25 |
| Averages ± SD of: | Shoot Length, mm | Shoot Number | Largest Leaf Width, mm | Number of Adventitious Roots | Number of Lateral Roots | Sum Length of Adventitious Roots, mm | Longest Adventitious Root, mm | Fresh Aboveground Biomass, g | Fresh Root Biomass, g | Dry Aboveground Biomass, g | Dry Root Biomass, g | Lateral Root Density, Number/mm |
|---|---|---|---|---|---|---|---|---|---|---|---|---|
| Uninoculated P. tremula | 43.3 ± 9.2 | 1.2 ± 0.5 | 9.6 ± 2.4 | 3.6 ± 1.4 | 26.0 ± 12.7 | 50.9 ± 18.1 | 25.1 ± 10.9 | 0.065 ± 0.024 | 0.024 ± 0.015 | 0.013 ± 0.005 | 0.003 ± 0.001 | 0.51 ± 0.21 |
| Inoculated P. tremula | 43.5 ± 6.2 | 1 ± 0.0 | 11.3 ± 1.4 | 4 ± 1.1 | 37.7 ± 9.7 (↑44.7%) | 47.6 ± 16.4 | 18.9 ± 7.7 | 0.075 ± 0.012 | 0.049 ± 0.021 (↑101.9%) | 0.015 ± 0.002 | 0.004 ± 0.002 (↑63.6%) | 0.85 ± 0.27 (↑66%) |
| Student’s t-test | NS | NS | ** | NS | ** | NS | * | NS | **** | * | *** | **** |
| ANOVA | NS | NS | NS | NS | F (11.3), ** | NS | NS | NS | F (19.4), **** | NS | F (15.4), *** | F (20.1), **** |
| Uninoculated P. tremula × P. alba | 48.2 ± 14.2 | 1.0 ± 0.2 | 9.8 ± 2.3 | 1.6 ± 0.6 | 10.8 ± 13.0 | 34.9 ± 20.6 | 26 ± 14.9 | 0.157 ± 0.05 | 0.018 ± 0.021 | 0.028 ± 0.009 | 0.002 ± 0.002 | 0.23 ± 0.23 |
| Inoculated P. tremula × P. alba | 39.1 ± 12.1 | 1.0 ± 0.2 | 11.3 ± 2.8 | 2.7 ± 1.4 (↑65%) | 33.7 ± 16.0 (↑213.7%) | 70.5 ± 32.1 (↑102%) | 46.7 ± 20.7 (↑79.5%) | 0.118 ± 0.029 (↓25%) | 0.053 ± 0.043 (↑197.1%) | 0.022 ± 0.007 | 0.006 ± 0.004 (↑144.8%) | 0.52 ± 0.26 (↑125.6%) |
| Student’s t-test | NS | NS | NS | *** | **** | *** | *** | ** | ** | * | *** | *** |
| ANOVA | NS | NS | NS | F(11.7), ** | F(27.4), **** | F(19.5), **** | F(14.7), *** | F(9.9), ** | F(12.2), ** | NS | F(17.1), *** | F(15.0), *** |
Publisher’s Note: MDPI stays neutral with regard to jurisdictional claims in published maps and institutional affiliations. |
© 2021 by the authors. Licensee MDPI, Basel, Switzerland. This article is an open access article distributed under the terms and conditions of the Creative Commons Attribution (CC BY) license (https://creativecommons.org/licenses/by/4.0/).
Share and Cite
Vaitiekūnaitė, D.; Kuusienė, S.; Beniušytė, E. Oak (Quercus robur) Associated Endophytic Paenibacillus sp. Promotes Poplar (Populus spp.) Root Growth In Vitro. Microorganisms 2021, 9, 1151. https://doi.org/10.3390/microorganisms9061151
Vaitiekūnaitė D, Kuusienė S, Beniušytė E. Oak (Quercus robur) Associated Endophytic Paenibacillus sp. Promotes Poplar (Populus spp.) Root Growth In Vitro. Microorganisms. 2021; 9(6):1151. https://doi.org/10.3390/microorganisms9061151
Chicago/Turabian StyleVaitiekūnaitė, Dorotėja, Sigutė Kuusienė, and Emilija Beniušytė. 2021. "Oak (Quercus robur) Associated Endophytic Paenibacillus sp. Promotes Poplar (Populus spp.) Root Growth In Vitro" Microorganisms 9, no. 6: 1151. https://doi.org/10.3390/microorganisms9061151
APA StyleVaitiekūnaitė, D., Kuusienė, S., & Beniušytė, E. (2021). Oak (Quercus robur) Associated Endophytic Paenibacillus sp. Promotes Poplar (Populus spp.) Root Growth In Vitro. Microorganisms, 9(6), 1151. https://doi.org/10.3390/microorganisms9061151
